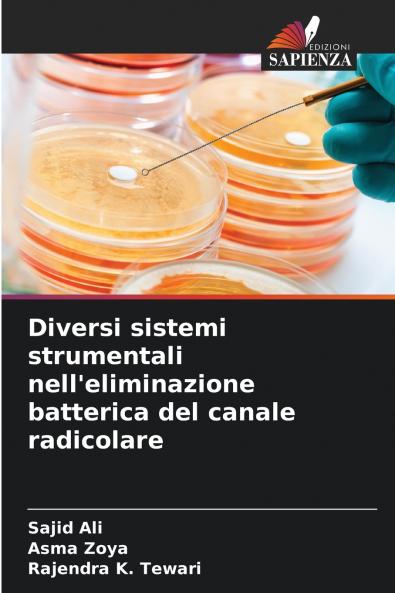
Diversi sistemi strumentali nell'eliminazione batterica del canale radicolare

Italian
Paperback
₹5060
₹5448
7.12% OFF
(All inclusive*)
Delivery Options
Please enter pincode to check delivery time.
*COD & Shipping Charges may apply on certain items.
Review final details at checkout.
Looking to place a bulk order? SUBMIT DETAILS
About The Book
Description
Author(s)
I cambiamenti patologici nella polpa e nei tessuti periapicali sono dovuti ai microrganismi e ai loro sottoprodotti. Per ottenere una guarigione ottimale dei tessuti periapicali e una migliore prognosi del trattamento endodontico l'obiettivo principale della terapia endodontica è l'eliminazione completa dei microrganismi dei loro sottoprodotti e dei tessuti infetti. La strumentazione meccanica l'irrigazione antimicrobica e i medicamenti intracanalari sono i metodi comunemente utilizzati per eliminare la carica microbica intracanalare. Tuttavia la strumentazione meccanica rimane ancora il pilastro della disinfezione canalare in quanto fornisce una piattaforma per l'azione degli altri due metodi. Sono stati compiuti continui progressi negli strumenti rotanti in nichel-titanio dalla loro introduzione in endodonzia quasi vent'anni fa. ProTaper Next K3XF e Hyflex CM sono strumenti rotanti di recente introduzione realizzati mediante trattamento termomeccanico delle leghe NiTi. Lo scopo del presente studio era valutare l'efficacia di questi sistemi rotanti NiTi e degli strumenti manuali Hero Shaper e Nitiflex file nella riduzione della popolazione di Enterococcus faecalis all'interno dei canali radicolari.
Delivery Options
Please enter pincode to check delivery time.
*COD & Shipping Charges may apply on certain items.
Review final details at checkout.
Details
ISBN 13
9786209221446
Publication Date
-06-11-2025
Pages
-52
Weight
-85 grams
Dimensions
-152x229x3.16 mm